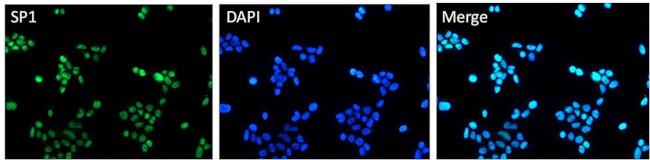
SP1 Antibody in Immunocytochemistry (ICC/IF)

Search
Invitrogen
SP1 Polyclonal Antibody
{{$productOrderCtrl.translations['antibody.pdp.commerceCard.promotion.promotions']}}
{{$productOrderCtrl.translations['antibody.pdp.commerceCard.promotion.viewpromo']}}
{{$productOrderCtrl.translations['antibody.pdp.commerceCard.promotion.promocode']}}: {{promo.promoCode}} {{promo.promoTitle}} {{promo.promoDescription}}. {{$productOrderCtrl.translations['antibody.pdp.commerceCard.promotion.learnmore']}}
图: 1 / 9
SP1 Antibody (PA1-25578) in ICC/IF









Please note: We are reviewing Western blot images included in the antibody testing data in our catalog, including those provided by third parties. Unless expressly labeled or annotated as “raw-unedited”, Western blot images included in the antibody testing data in our catalog may have been edited, optimized or otherwise adjusted for presentation.
产品信息
PA1-25578
宿主/亚型
分类
类型
抗原
偶联物
形式
浓度
规格
保存条件
运输条件
产品详细信息
PA1-25578 detects SP1 from human samples. PA1-25578 is expected to cross react with mouse (96% conserved), rat, Xenopus laevis (86% conserved), bovine (98% conserved), zebrafish (100% conserved), chicken (88% conserved), and porcine (95% conserved) due to sequence homology.
PA1-25578 has been successfully used in Western blot, FACS, IHC and immunoprecipitation procedures. The predicted molecular weight of PA1-25578 is 90 kDa.
The PA1-25578 immunogen is a synthetic peptide corresponding to the C-terminal within the region between residues 750-785 of human SP1.
靶标信息
SP1 is a transcription factor that can activate or repress transcription in response to physiological and pathological stimuli. Binds with high affinity to GC-rich motifs and regulates the expression of a large number of genes involved in a variety of processes such as cell growth, apoptosis, differentiation and immune responses. Highly regulated by post-translational modifications (phosphorylations, sumoylation, proteolytic cleavage, glycosylation and acetylation). Binds also the PDGFR-alpha G-box promoter. May have a role in modulating the cellular response to DNA damage. Implicated in chromatin remodeling. Plays a role in the recruitment of SMARCA4/BRG1 on the c-FOS promoter. Plays an essential role in the regulation of FE65 gene expression.
仅用于科研。不用于诊断过程。未经明确授权不得转售。